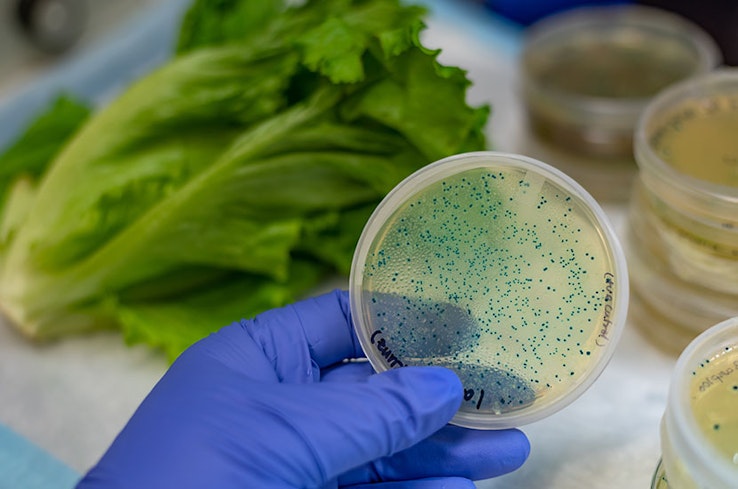
Recalls width
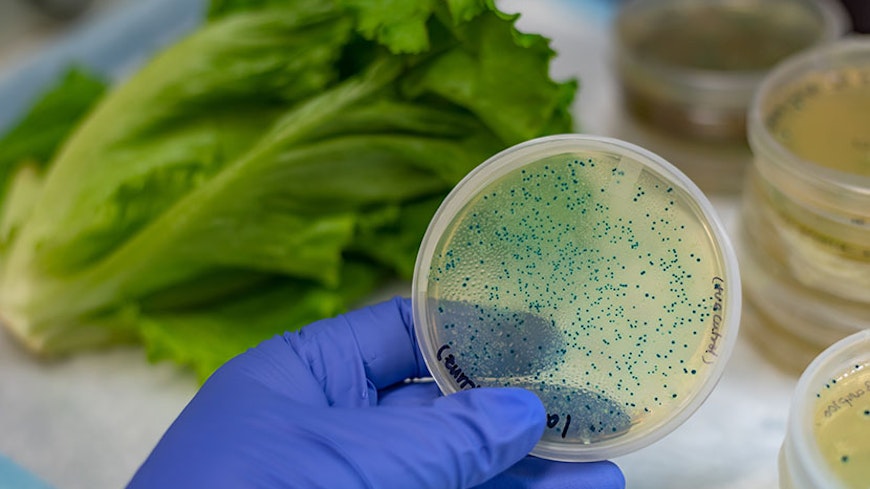
Recalls width

By Kate Harvey
Content Manager | Pou Whakahaere Ihirangi
Sausages that might contain pieces of blue plastic, ham contaminated with listeria, and mac and cheese meals that may have the added crunch of stones and metal. These are some of the dozens of foods recalled in New Zealand so far this year.
While most of the food we buy and eat will be completely safe, every now and then things can go wrong. When they do, a food might be recalled. This means it’s taken off the shelves so it can’t be bought anymore, and a plan is made to let the public know not to consume it if they have bought it. This usually involves:
putting up posters at the places the product was sold
running advertisements using social media
New Zealand Food Safety putting the information on its website and sending an email to people who have signed up to receive recall notices.
Why is food recalled?
Jenny Bishop is director of food compliance and response at New Zealand Food Safety and knows the details of recent recalls. She took us through the five most common reasons a food gets recalled in New Zealand.
1. Unlabelled allergens
The most common reason for a recall is when a food contains an unlabelled ingredient that could cause an allergic reaction, such as dairy, gluten or egg. For most people this won’t pose a food safety risk, but for people who live with allergies it can be a life-threatening mistake.
EXAMPLE: In August, a mix-up on a production line saw some cheese-flavoured corn chips packaged in the company’s natural-flavoured corn chip bags. This posed a risk for people allergic to milk, as the allergen wasn’t declared on the packaging. Bishop said a specific batch was recalled, while food safety officers worked with the company to ensure it couldn’t happen again.
2. Biological contamination
Food being contaminated with microbes that can make us sick, such as campylobacter, listeria and salmonella, was responsible for about 27% of recalls in 2022.
EXAMPLE: Tahini is a paste made from sesame seeds and is used to make hummus. It’s also recognised as a high-risk food and there are requirements to be met for importing it into New Zealand. Dozens of tahini and hummus products, made by multiple brands, have had to be recalled this year because of possible salmonella contamination. Imported frozen berries linked with hepatitis A are another high-profile recall from recent years. Hepatitis A can cause serious illness.
3. Foreign matter
The presence of foreign matter, such as plastic, glass and metal, in a food was the cause of about 17% of recalls in 2022.
EXAMPLE: In August this year, a batch of kombucha was recalled because an issue during bottling meant the drink could contain glass pieces.
4. Incorrect labelling
Bishop says recalls due to incorrect labelling are usually about incorrect use-by dates but can also be because of other errors.
EXAMPLE: In 2022, lemonade was mistakenly sold in soda water bottles. The soda water bottles didn’t state the lemonade contained phenylalanine – an amino acid that can cause health issues for people with a genetic condition – so had to be recalled.
5. Chemical contamination
About 7% of recalls in 2022 were because the food had become contaminated with chemicals.
EXAMPLE: In 2022, a baby purée powder that contained kelp was recalled because of high iodine levels. Iodine is an essential part of our diets, but you can have too much or too little.
How do I find out if a food has been recalled?
When a food is recalled, a business must try and get the message out to people who have bought it. This is done through notices in shops and sometimes through advertisements and social media.
But there’s an easy way to find out about a recall as soon as it’s made and without waiting to come across it by chance. You can view all recent recalls and subscribe to get recalls by email.
You can also tailor your subscription to just receive notices for recalls relating to food allergens.
“It’s my hope that every household will sign up to receive the recall alerts,” Bishop said. “The alerts mean you get the information at whatever hour of the day they happen. This has the potential to prevent illness, serious injury and allergic reactions.”
What do I do with a recalled food?
A recall notice will tell you what to do with a food that has been recalled. Usually the advice is to throw it out or return it to the store for a refund.
How do I report a food issue?
If you discover something wrong with food, you can contact the store you bought it from or the business that makes it, or call New Zealand Food Safety on 0800 00 83 33.
Once an issue has been raised, New Zealand Food Safety works with manufacturers, suppliers, importers and distributors to decide if a recall is needed.
If a business needs to recall a food, but fails to do so, New Zealand Food Safety can make it recall the product by law. This doesn’t occur often as most businesses do a recall when required. Bishop said 67% of recalls in 2022 had originated from the food industry rather than a consumer. “It shows the vast majority want to do the right thing and look after consumers.”

Subscribe to our newsletters
Get even more Consumer NZ news and invitations to share your voice on important issues straight to your inbox. You don’t have to be a member to have these newsletters emailed to you regularly.



